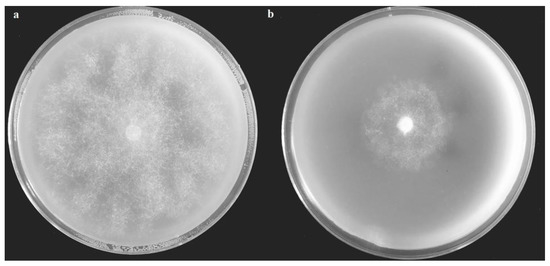
Agronomy 10 00770 g0a1

Abstract
The present study evaluated the fumigant effect and potential mechanisms of Chinese prickly ash seed kernel (PSK) against tobacco black shank caused by Phytophthora nicotianae Breda de Haan. The results showed that PSK fumigant increased the soil organic matter, hydrolysable nitrogen, available potassium, and total phosphorus significantly, while the pH was decreased. Application of 2% PSK promoted plant growth, with higher plant height, root length, and dry weight compared to those in the treatment with no PSK. Both in vitro and in vivo tests indicated that PSK fumigant effectively inhibited mycelial growth of P. nicotianae, and significantly reduced the severity of tobacco black shank. Based on the analysis of volatiles in PSK by headspace solid-phase microextraction (HS-SPME) gas chromatography-mass spectrometry (GC-MS), 28 components were identified, among which monoterpenes were the major components (accounting for 79.46% of peak area). Among the six top components, linalool, piperitone, sabinene, and limonene exhibited strong mycelial inhibition of P. nicotianae. Linalool was the most effective with an IC50 value of 18.03 μL/L. Results of GC-MS revealed that the main components of PSK extract were cis-Vaccenic acid (40.81%), n-Hexadecanoic acid (15.67%), 9,12-Octadecadienoic acid (Z,Z)- (15.25%), Ethanone-1-(2-hydroxy-4,6-dimethoxyphenyl)- (10.32%), cis-9-Hexadecenoic acid (6.21%), and Psilocin (11.75%). Among them, Ethanone-1-(2-hydroxy-4,6-dimethoxyphenyl)- and 9,12-Octadecadienoic acid (Z,Z)- have an obvious inhibitory effect on P. nicotianae. Additionally, changes in soil bacterial and fungal communities were observed. The relative abundance of some microbes, such as Pseudomonas, Azospirillum, Thermomonas, Glutamicibacter, Dyella, and Trichoderma, increased, which have many beneficial microbes in these genera, indicating that microbial community shift could be one of the important outcomes of the PSK fumigant effect. In conclusion, PSK could be a new bio-fumigation material against plant soilborne pathogens, which can function as both a fungicide and fertilizer.
1. Introduction
Tobacco black shank is a critical soilborne oomycete disease caused by Phytophthora nicotianae Breda de Haan [1]. In China, the epidemic area of the disease is more than 76,372 ha, and the direct economic loss is above a billion dollars. Currently, the application of chemical fungicides, such as Metalaxyl Mancozeb, is the main control method, which has caused a series of problems, including high pesticide residues in tobacco leaves, environmental pollution, and pathogenic resistance to fungicides [2]. The increasing concern about the environment and human health prompted a general desire to reduce such fungicide inputs, and hence, the development of other effective, eco-friendly control methods has been a very urgent issue.
Recently, there is a growing interest in bio-fumigation, which is recognized as a new agro-ecological approach for soilborne disease management [3]. Bio-fumigation is defined as a method to suppress soilborne pests and diseases using volatiles produced by organic substances (such as plant residues) [4] as well as some microbes [5]. Crops from Brassicaceae and Asteraceae are the main plants used as biofumigants. These plants contain secondary plant metabolites called glucosinolates (GSLs), which are believed to be involved in plant defense. As Brassica crops produce nitriles, thiocyanates, and isothiocyanates (ITCs), they have been used to control a range of soilborne pests and pathogens [6,7]. However, studies on other plants with bio-fumigation potential are limited [8,9]. In addition, previous studies mainly focused on the selection and disease suppression effects of fumigation materials, but reports of their effects on soil nutrients and microbial community were fewer [10].
Chinese prickly ash (Zanthoxylum bungeanum) is an important economic crop in China, with an annual planting area of about 1,000,000 hectares. Recently, there is an increasing interest in the cultivation of Chinese prickly ash owing to its great economic significance (important condiment and traditional Chinese medicine) as well as ecological value (such as the greening of barren hills and rocky desertification control). The prickly ash seed kernel (PSK), known as Jiaomu in Chinese traditional medicine, is the seed of Chinese prickly ash after drying and peeling. As the main by-product of the prickly ash industry, more than 1.5 billion kilograms are discarded as agricultural waste annually, which results in the wastage of the natural resource. In fact, PSK is rich in nutrients and bioactive components, and its anthelmintic function has been recognized by the Chinese since ancient times.
Recent studies revealed that proper application of PSK can not only improve the physical and chemical properties of soil, promote the growth of tomato plants but also effectively inhibit the occurrence of root-knot nematodes. The killing mechanism is mainly attributed to the rich D-limonene and linalool in PSK [11]. Therefore, the study of PSK as soil fumigant is of great significance. However, few reports have described the fumigation effect of PSK on soilborne pathogens. We evaluated the fumigation efficacy of PSK, identified potential antimicrobial components, discussed the possible fumigation mechanism, and analyzed the effect of PSK on soil microbial ecology.
2. Materials and Methods
2.1. Biological Materials
PSK of Zanthoxylum bungeanum, commonly called Dahongpao, the main local cultivar, were collected from the Shanting District, Shandong province of China. Phytophthora nicotianae (Pn) strain JM01, the pathogen, was maintained in our laboratory [12]. The tested tobacco variety was “Xiaohuangjin 1025”, which is susceptible to tobacco black shank disease.
2.2. HS-SPME GC-MS Method
The extract of PSK was prepared by ethanol–petroleum ether method, according to Dong et al. (2016) [13]. Headspace solid-phase microextraction (HS-SPME) was chosen as the method for volatile compound sampling. The so-called sandwich-type (Divinylbenzene/Carboxen/Polydimethylsiloxane, Supelco, Bellefonte, PA, USA) fiber was used for the absorption of PSK volatile compounds. For sampling volatile compounds, the SPME fiber was inserted into the headspace of sample vial containing 10 g PSK at 25 °C for 20 min. When the sampling was completed, the SPME fiber was then removed from the sample vial and immediately inserted into the gas chromatography (GC) injector at 250 °C for 5 min with a split ratio of 10:1. The used SPME fiber was conditioned at 250 °C for 5 min prior to the next sampling.
The gas chromatography-mass spectrometry (GC-MS) analyses were done with an Agilent 7890–5975C GC-MSD system (Santa Clara, CA, USA) with a DB-5 MS fused-silica capillary column (30 m × 0.25 mm i. d, 0.25 μm film thickness). The injection volume was 1.0 μL in split less mode with an inlet temperature of 250 °C, and helium was used as the carrier gas at a flow rate of 1.0 mL min−1. The analyses were carried out in programmed mode, the initial oven temperature was held at 45 °C for 2 min, ramped to 200 °C at 5 °C/min, held for 2 min, ramped to 320 °C at 15 °C/min, then held for 3 min. The transfer line, the ion source, and quadrupole analyzer temperatures were 280, 230, and 150 °C, respectively. The ionization mode was the electron impact at 70 eV. The mass spectra plot was acquired using full scan monitoring mode with a mass scan range of m/z 35-450. The acceleration voltage was turned on after a solvent delay of 3 min. The GC analyses were done with an Agilent 7890 GC system. The flame ionization detector (FID) detector temperature was set to 300 °C and the same operational conditions applied to a duplicate of the same column used in GC/MS analyses. The flow rate of carrier gas was adjusted to obtain the same retention times with GC/MS analyses.
2.3. Chemical Composition of PSK Volatiles and Extracts
The identification of volatile components was based on the calculated retention indices (RI) and on the comparisons of obtained mass spectra with those of reference compounds, available in the NIST (National Institute of Standards and Technology, Gaithersburg, MD, USA) library. The retention indices were determined in relation to a homologous series of n-alkanes (C7–C30) under the same operating conditions. The relative percentage amounts of the separated compounds were calculated from the integration of the peaks in flame ionization detector (FID) chromatograms.
2.4. Mycelia Inhibition Effect of PSK Volatiles and Extracts
Extracts of PSK and its five main constituents(cis-Vaccenic acid, n-Hexadecanoic acid, 9,12-Octadecadienoic acid (Z,Z)-, Ethanone-1-(2-hydroxy-4,6-dimethoxyphenyl)-, and cis-9-Hexadecenoic acid) were evaluated for fumigation effect on Pn with flat plate confrontation method [14]. PSK and its five main constituents (sabinene, piperitone, limonene, linalool, and myrcene) were evaluated for fumigation effect on Pn mycelial growth with a modified sealed-plate method. A mycelial disc (5 mm) was inoculated to the center of an OA (oatmeal agar) plate, and PSK powders (1, 2, 4, 6 g, respectively) and the diluted constituents (4.92, 9.84, 19.69, 39.37, 78.74, 157.48, and 314.96 μL/L) were added to the Petri dish cover, sealed with parafilm, incubated at 28 °C for 4 days, and the colony diameter was determined using the cross–cross method [14]. Each treatment was repeated three times, and the plate with no PSK or constituent addition served as a control. Mycelial growth inhibition rate was calculated according to Han et al. (2019) [15].
2.5. Pot Experiment
The method of Pn inoculum preparation was as follows. The millets were boiled with water until two-thirds of the seed hulls were ruptured. Filtrated with gauze, aired (with 15% of water content), and placed in flasks for sterilization (121 °C, 20 min). Pn was reactivated on oatmeal agar (OA) medium for seven days. Then, mycelial discs (diameter 5 mm, 3 discs per flask) were inoculated on millet medium and incubated for 14 days at 26 °C.
Soil for the experiment was from the field of Jimo base, Tobacco Institute, Chinese Academy of Agricultural Sciences, type loam, which was sterilized by dry-heat method (160 °C for 5 h). After cooling, the pathogenic soils (PS) were prepared by blending the millet with Pn infection (5 g per kg). PSK were powdered, sieved, and added to the pathogenic soils (2% and 6% PSK content). Soils with no PSK addition served as control. The soils were covered with plastic film for 30 d, each treatment with 15 tobacco seedlings (1 plant and 20 kg of soil per pot)—all with three replicates. The disease index was calculated at 10 d and 20 d, according to Han et al. (2016) [16], with the agronomic characters measured at 30 d. Three plants were randomly selected from each treatment for measurement. Then soils were sampled to analyze chemical indices. The pH value of soil water extract (soil:water, 2.5:1) was measured using the potentiometric method. The electrical conductivity (EC) was measured by the Shanghai Thunder Magnetism DDS-11A Conductivity Meter (Shanghai, China). Soil chemical properties were determined according to the method described by Bao (2005) [17]. The soil organic matter content was determined by oxidation–reduction–titration using furnace digestion. Soil alkali-hydrolyzed nitrogen (AN) content was determined by the alkali-hydrolyzed diffusion method. The NaHCO3 extraction Mo-Sb anti-spectrophotometry method was used to determine the available phosphorus (AP) in soil, and the total phosphorus (TP) was assayed with the alkali fusion-MO-Sb anti-spectrophotometric method. The available potassium (AK) was measured by the NH4OAc (1 M) extraction–flare photometer method. All with three replicates.
2.6. Effect of PSK on Soil Microbial Community
DNA of rhizosphere soil [18] was extracted and purified by a DNeasy® PowerSoil® Kit (Qiagen, Hilden, Germany). The total soil DNA was amplified using the bacterial V4 region of 16S rRNA genes (515F and 806R) primer) and fungal ITS1 (internal transcribed spacer) region of 18S rRNA genes (ITS5-1737F, ITS2-2043R). All PCRs were carried out with a Phusion® High-Fidelity PCR Master Mix (New England Biolabs, Ipswich, MA, USA). PCR products were purified with a Gene JETTM Gel Extraction Kit (Thermo Scientific, Waltham, MA, USA). Finally, 250 bp paired-end sequencing and construction of the gene clone libraries were performed at Novogene (Beijing, China) using the Illumina HiSeq 2500 platform. Three plants were randomly selected for sampling in each treatment.
Quality filtering of the raw tags was performed under specific filtering conditions to obtain high-quality clean tags [19], according to the Quantitative Insights Into Microbial Ecology (QIIME) (http://qiime.org/index.html) [20] quality-controlled process. The chimera sequences were removed using the Ultra-fast sequence analysis (UCHIME) (http://www.drive5.com/usearch/manual/uchi-me_algo.html) [21]. The obtained effective tags were clustered and annotated with Uparse (http://drive5com/uparse/). Each operational taxonomic unit (OTU) was defined as a cluster of reads with a 97% sequence identity. For each representative bacterial sequence, the Silva Database (http://www.arb-silva.de/) was used based on the Mothur algorithm to annotate taxonomic information, with the fungal sequence annotated by UNITE (v 7.2) Database (https://unite.ut.ee/). Alpha diversity is used to analyze the complexity of species diversity for a sample through observed species, Chao1, Shannon, and ACE. For our samples, all of these indices were calculated with QIIME (Version 1.7.0), and were displayed using R software (Version 2.15.3).
Nonmetric multidimensional scaling (NMDS) of the microbial communities based on OTU composition was carried out using the Bray–Curtis similarity metric in the Past software package, version 2.03 [22]. Analysis of molecular variance (AMOVA) is a nonparametric analysis method, which can test the significance of differences between groups based on the distance between samples. AMOVA analysis used the AMOVA function of Mothur software.
Canonical correspondence analysis (CCA, used CCA function in the vegan package) was used to display the relationship between microbial group (at genus level), soil chemical properties (soil pH, organic matter, hydrolyzable nitrogen), and disease index. CCA was performed using R-2.15.3 for Windows. The Mantel test used the vegan package in R, according to the species matrix and the data matrix of environmental factors provided. The vegdist function was used to transform the distance matrix of the two kinds of data, and then the mantel function was used to analyze the Spearman correlation of the two kinds of matrices to get the r and P values.
2.7. Data Analysis
Microsoft Office Excel 2016 was used for data processing; IBM SPSS Statistics version 24.0 was used for variance analysis and correlation analysis. Significance was evaluated at P < 0.05 for all tests. The results of the assays of inhibitory activity, soil properties, and disease index are presented as the means ± standard error of triplicate experiments. The half-maximal inhibitory concentration (IC50) values were calculated using regression analysis of the logarithmic values of component concentrations and probability values of the corresponding inhibition rate. Analysis of variance (ANOVA) and multiple comparisons were performed using Duncan’s method. Evaluations with P < 0.05 were considered significant.
3. Results and Discussion
3.1. Components of PSK Volatiles and Extracts
GC-MS revealed that the main components of PSK extract were cis-Vaccenic acid (40.81%), n-Hexadecanoic acid (15.67%), 9,12-Octadecadienoic acid (Z,Z)- (15.25%), Ethanone-1-(2-hydroxy-4,6-dimethoxyphenyl)- (10.32%), cis-9-Hexadecenoic acid (6.21%), and Psilocin (11.75%) (Table A1). Based on HS-SPME GC-MS analysis, 28 components were identified, representing 89.85% of PSK volatiles (Table 1). These volatiles belonged to alcohols (2), aldehydes (5), ketones (2), monoterpenes (18), and sesquiterpenes (1). Monoterpenes were the major components, accounting for 79.46% of the peak area. The compounds observed in higher percentages (> 5%) were sabinene, D-limonene, β-Myrcene, β-phellandrene, piperitone, and linalool. There were another 10 constituents with a proportion of more than 2%, α-pinene, α-terpinene, β-cis-ocimene, γ-terpinene, trans-sabinene hydrate, terpinolene, nonanal, L-4-terpineol, α-terpineol, and xanthoxylin. Additionally, two unknown components accounted for 10.15%. Previous studies have investigated the volatile compositions of the pericarp and essential oil from dried Z. bungeanum [23,24]. To our knowledge, this is the first report to identify the volatile components of PSK. However, most of the volatiles reported were associated with Zanthoxylum in previous studies [23,25]. In line with our results, Sriwichai et al. (2019) [26] found that sabinene, terpinene-4-ol, L-limonene, β-phellandrene are dominant constituents of essential oils extracted from Z. myriacanthum dried fruit. Similarly, Fu et al. (2018) [27] observed that linalool and D-limonene were major volatiles obtained from dried Z. bungeanum fruit. It is worth pointing out that fewer components were detected in PSK volatiles than in the pericarp volatiles and essential oils from Z. bungeanum [23]. The above results indicated that the PAS contained similar major volatiles, but different contents compared to that in the pericarp. Interestingly, xanthoxylin, a valuable component found in the pericarp, was also detected in PSK volatiles, further proving the beneficial effects of using PSK. Xanthoxylin has been reported to have antibacterial and insecticidal activities [27,28].

Table 1.
Volatile composition of prickly ash seed kernel by headspace solid-phase microextraction fiber combined with gas chromatography coupled with flame ionization detection.
3.2. Antifungal Effects of PSK Against Phytophthora Nicotianae
Among components of extract, Ethanone-1-(2-hydroxy-4,6-dimethoxyphenyl)- and 9,12-Octadecadienoic acid (Z,Z)- have an obvious inhibitory effect on P. nicotianae, and an antifungal belt is obvious around the dosing hole. But other compounds had no observed effect. The sealed-plate experiment revealed that the volatile components of PSK exhibited inhibitory activity on the growth of P. nicotianae mycelia (Table A2 and Table 2). As shown in Figure A1, the mycelia of the control were even and dense (Figure A1-a), while the mycelia treated with PSK grew slowly and loosely (Figure A1-b). The inhibitory effect increased with the increase in the number of prickly ash seeds. The inhibition rate of 6 g/plate PSK was 63.1% (Table A2). In corroboration with the in vitro experiment, the pot experiment also proved that the PSK had an obvious fumigant effect on Pn. Compared to the control, the addition of 2% and 6% PSK decreased the incidence of the disease by 76.47% and 85% after 10th days of inoculation, respectively (Figure 1). These results indicated that PSK could be a potential fumigant against tobacco black shank.

Table 2.
Toxicity measurement of major volatile components on P. nicotianae.

Figure 1.
Control effect of prickly ash seed kernel on tobacco black shank disease. Values are the means of three replicates ± SD. Values within the same column, followed by different lowercase letters, are significantly different (P < 0.05).
The in vitro fumigant activity of PSK can be attributed to its volatile components, especially the higher proportions of monoterpenes. As shown in Table 2, four of the six main constituents (peak area percentage over 6%) tested exhibited strong inhibitory activity against P. nicotianae. Among them, linalool was the most effective one with IC50 of 18.03 μL/L, followed by piperitone (51.99 μL/L), and sabinene (172.88 μL/L). Limonene was less effective with an IC50 value of 448.15 μL/L, while myrcene showed no obvious inhibition effect.
Previous studies have revealed that the major volatiles of PSK had inhibitory activity against different fungi. Limonene and α-pinene were reported to inhibit the growth of Candida, Cryptococcus, Aspergillus, and dermatophyte species [29]. Espinosa-García and Langenheim (1991) [30] found that sabinene and γ-terpinene exhibited a growth inhibition ability against seven fungal endophytes on coastal redwood leaves. Glamoclija et al. (2009) [31] reported that α-pinene and limonene showed a fumigant effect against the mushroom pathogen Mycogone perniciosa with minimal inhibitory quantities of 5 and 1 µL/disc, respectively. Tampieri et al. (2005) [32] proved that β-phellandrene had a strong inhibitory activity (MIC = 50 ppm) against Candida albicans. Similarly, piperitone was observed to inhibit plant pathogens, including Rhizoctonia solani, Pythium debaryanum, Botrytis fabae, and Fusarium oxysporum. Other monoterpenes, such as linalool, α-terpineol, and α-terpinene, were also reported to have antifungal activities [22,33,34]. Overall, PSK contains several antifungal volatiles, and its fumigant effect may be attributed to these constituents either acting independently or in combination.
3.3. Effects of PSK Fumigant on Plant Growth
As shown in Figure 2, the addition of 2% PSK promoted the growth of tobacco, such as higher plant height, root length, and dry weight. This effect may be attributed to soil nutrient improvement. Rahman et al. (2011) [35] reported that the application of two brassica green manure increased soil organic matter. Similarly, Marchetti et al. (2015) [10] found that biofumigant plant materials Brassica carinata and Brassica juncea (containing glucosinolate) improved the soil N availability. In line with the result in previous studies, PSK treatment increased the soil organic matter, hydrolyzable nitrogen, and available potassium (Table 3). The total phosphorus increased while available phosphorus decreased, suggesting that a large amount of phosphorus is immobilized in the soil. The soil pH was also altered, which decreased with increasing amounts of PSK. Our results suggested that PSK has the potential to be used as not only a fumigant but also as a green manure. However, excessive addition of PSK (≥6%) inhibited plant growth, indicating the existence of allelochemicals.

Figure 2.
Growth promoting effect of prickly ash seed kernel on tobacco. Values are the means of three replicates ± SD. Values within the same column, followed by different lowercase letters are significantly different (P < 0.05).

Table 3.
Effects of prickly ash seed kernel (PSK) on soil chemical properties.
3.4. Effects of PSK Fumigant on Soil Microbial Community Richness and Diversity
A total of 721,657 fungal sequences (T6, 240,640; T2, 240,320; CK, 240,697) and 721,975 bacterial sequences (T6, 240,684; T2, 240,809; CK, 240,482) were queried after quality filtering, with an average read length of 412–415 bp for bacteria and 230–252 bp for fungi. The rarefaction curves at 3% dissimilarity indicated that the operational taxonomic unit (OTU) number of both fungi and bacteria (Figure 3) decreased with PSK fumigation. In accordance with this, the richness and diversity values were also reduced, and the reduction showed an obvious dose–effect relationship with PSK. Treatment with 6% PSK resulted in the lowest α-diversity of both bacteria and fungi (Table 4).

Figure 3.
Rarefaction curves of bacterial 16S rRNA genes (A) and fungal ITS sequences (B) of 97% similarity from soils with prickly ash seed kernel (PSK) fumigant. T2, 2% of PSK amendment; T6, 6% of PSK amendment; CK, control with no PSK amendment. Bars above the scatter points represent the standard error of three replicates.

Table 4.
Alpha diversity index of bacteria and fungi operational taxonomic unit (OTU) in soil samples treated with different amounts of prickly ash seed kernel.
Suppression of soil bacterial or fungal populations by bio-fumigation was reported in several previous studies [36,37,38]. Ma et al. (2018) [39] used Tagetes erecta powder for soil fumigation and found that the diversity and richness index of fungi decreased. Interestingly, our results also indicated that compared to bacteria, the fungi were more susceptible to PSK treatment. The Shannon, Chao1, and ACE indices of bacteria with the addition of 2% PSK were not significantly different from those of the control, while that of fungi were obviously lower compared to that of the control.
3.5. Effect of PSK Fumigant on Microbial Structure
The relationship between all soil microbial community compositions was illustrated by NMDS analysis (Figure 4). The NMDS plot showed that three randomly collected replicates from each treatment were usually located closely. The bacterial (Stress = 0.045) and fungal (Stress = 0.001) community of the high PSK (6%), low PSK (2%), and no PSK (control) treatments were well separated from each other, indicating that the composition of the soil microbial community was altered in response to the bio-fumigation treatments.

Figure 4.
Nonmetric multidimensional scaling (NMDS) graphs of soil fungal (A) and bacterial (B) communities 30 d after the application of PSK fumigant. P-value was obtained by analysis of molecular variance (AMOVA) analysis (unweighted_unifrac).
According to the result of the Mantel test, the soil parameters that were significantly correlated with the bacterial and fungal community structures were selected for the CCA analysis (Figure 5). The microbial communities shifted with PSK amendment along CCA1 and CCA2, respectively. Among all the tested environmental variables, organic matter (OC), hydrolyzable nitrogen (N), pH, and disease index (DI) were relatively near CCA1 which explains the 60.22% variation in fungal communities (r = 0.4946, P = 0.001) and 58.15% in the bacterial communities (r = 0.4919, P = 0.001). PSK (6% and 2%) fumigant treatment increased (P < 0.05) the relative abundance of bacterial species Pseudomonas, Azospirillum, Thermomonas, Glutamicibacter (6% PSK), and Dyella (6% PSK) as well as the fungal species Trichoderma, Mortierella, and Aspergillus (6% PSK) (Figure A2).

Figure 5.
Results from canonical correspondence analysis (CCA) to explore the relationship between microbial populations and selected environmental factors in the soil. (A) Bacterial; (B) Fungal. OC, organic matter; N, hydrolyzable nitrogen; DI, disease index.
To the best of our knowledge, the present study is the first to detail the effects of PSK on soil microbial communities. Therefore, the corroboration of results is not possible. Nevertheless, our findings were partially supported by several related studies. Hu et al. (2015) [40] found that different types of isothiocyanates resulted in significant changes in fungal community composition. Similarly, Weerakoon et al. (2012) [37] reported that modification of the fungal community by the addition of Brassica juncea seed meal might contribute to the long-term suppression of Pythium adappressorium. In line with our results, the increase in Aspergillus [38], Mortierella [40], and Trichoderma [37] were also observed in previous studies, which were believed to be more tolerant to bio-fumigation [41,42]. In line with the results of previous studies, with the application of lower PSK amount, the soil bacterial community was not severely affected [38,40]. Hollister et al. (2012) [36] found that bacteria related to fungal disease control (such as Bacillus, Pseudomonas, and Streptomyces) increased with the application of a glucosinolate-containing brassicaceous oilseed meal (Brassica juncea). PSK fumigant also increased the relative abundance of bacterial genera, which were reported to be associated with plant growth promotion or disease control [39,43,44]. Based on these results, we hypothesized that the microbial community shift following PSK application could be one of the important mechanisms for disease suppression.
4. Conclusions
Findings in the current study clearly demonstrated that the application of appropriate PSK (2%) is capable of effectively controlling tobacco black shank. The fumigant effect can be attributed to the volatiles released by PSK, such as linalool, piperitone, sabinene, and limonene. Moreover, PSK fumigation also significantly promoted tobacco growth and improved soil fertility (total P, hydrolysable N, and available K), exhibiting the effect of a fungicide and fertilizer. Interestingly, the shifts in microbial community structure showed increased proportions of bacterial taxa associated with pathogen suppression and plant growth promotion, suggesting that PSK can be applied in combination with certain biocontrol microbes.
From this study, we concluded that PSK could be a new bio-fumigation material against plant soilborne pathogens. However, long-term, field-scale studies are needed to evaluate the fumigation effect of PSK.
Author Contributions
Conceptualization, C.-S.Z. and M.L.; methodology, J.C.; software, Y.Z.; resources, X.H.; data curation and writing—original draft preparation, Y.W. All authors have read and agreed to the published version of the manuscript.
Funding
This research was funded by China National Tobacco Corporation, grant number 110201902003.
Conflicts of Interest
The authors declare no conflict of interest.
Appendix A
Figure A1.
Fumigant effect of prickly ash seed kernel on P. nicotianae mycelia growth. (a) Control; (b) 6 g/plate of PSK powders.

Figure A2.
Heatmap at genus level of soil bacterial (a) and fungal (b). T2, 2% of PSK amendment; T6, 6% of PSK amendment; CK, control with no PSK amendment.

Table A1.
Composition of the extract of prickly ash seed kernel by gas chromatography coupled with flame ionization detection.
Table A1.
Composition of the extract of prickly ash seed kernel by gas chromatography coupled with flame ionization detection.
| Compounds | Peak Area Percentage (%) | Identity (%) |
|---|---|---|
| Ethanone-1-(2-hydroxy-4,6-dimethoxyphenyl)- | 10.316749 | 94 |
| cis-9-Hexadecenoic acid | 6.208132 | 99 |
| n-Hexadecanoic acid | 15.668002 | 99 |
| Psilocin | 11.752521 | 90 |
| 9,12-Octadecadienoic acid (Z,Z)- | 15.248901 | 99 |
| cis-Vaccenic acid | 40.805695 | 99 |

Table A2.
Fumigant effect of prickly ash seed kernel on P. nicotianae mycelial growth.
Table A2.
Fumigant effect of prickly ash seed kernel on P. nicotianae mycelial growth.
| Addition of Prickly Ash Seed Kernel (g) | Inhibition Rate (%) |
|---|---|
| 1 | 35.19±0.99 d |
| 2 | 45.91±1.02 c |
| 4 | 52.05±0.87 b |
| 6 | 61.60±0.85 a |
Values are the means of three replicates ± SD. Values within the same column, followed by different lowercase letters are significantly different (P < 0.05).
References
- Panabières, F.; Ali, G.S.; Allagui, M.B.; Dalio, R.J.D.; Gudmestad, N.C.; Kuhn, M.; Roy, S.G.; Schena, L.; Zampounis, A. Phytophthora nicotianae diseases worldwide: New knowledge of a long-recognised pathogen. Phytopatho. Mediterr. 2016, 55, 20–40. [Google Scholar]
- Wang, H.C.; Chen, X.J.; Cai, L.T.; Cao, Y.; Lu, N.; Xia, H.Q.; Wang, M.S.; Shang, S.H. Race distribution and distribution of sensitivities to mefenoxam among isolates of Phytophthora parasitica var. nicotianae in Guizhou province of China. Crop Prot. 2013, 52, 136–140. [Google Scholar] [CrossRef]
- Reddy, P.P. Biofumigation. In Agro-ecological Approaches to Pest Management for Sustainable Agriculture; Springer: Singapore, 2017; pp. 43–59. [Google Scholar]
- Warmington, R.; Clarkson, J. Volatiles from biofumigant plants have a direct effect on carpogenic germination of sclerotia and mycelial growth of Sclerotinia sclerotiorum. Plant Soil 2016, 401, 213–229. [Google Scholar] [CrossRef]
- Goates, B.J.; Mercier, J. Control of common bunt of wheat under field conditions with the biofumigant fungus Muscodor albus. Eur. J. Plant Pathol. 2011, 131, 403–407. [Google Scholar] [CrossRef]
- Hansena, Z.R.; Keinath, A.P. Increased pepper yields following incorporation of biofumigation cover crops and the effects on soilborne pathogen populations and pepper diseases. Appl. Soil Ecol. 2013, 63, 67–77. [Google Scholar] [CrossRef]
- Madhavi, G.B.; Uma, D.G.; Kumar, V.K.; Babu, R.T.; Naidu, T.C.M. Evaluation of different brassica species and onion for their biofumigation effect against Rhizoctonia solani f. sp. sasakii in vitro. J. Res. Angrau 2015, 43, 22–28. [Google Scholar]
- Gong, B.; Bloszies, S.; Li, X.; Wei, M.; Yang, F.J.; Shi, Q.H.; Wang, X.F. Efficacy of garlic straw application against root-knot nematodes on tomato. Sci. Hortic. 2013, 161, 49–57. [Google Scholar] [CrossRef]
- Naz, I.; Palomares-Rius, J.E.; Khan, S.M.; Ali, S.; Ahmad, M.; Ali, A.; Khan, A. Control of Southern root knot nematode Meloidogyne incognita (Kofoid and White) Chitwood on tomato using green manure of Fumaria parviflora Lam (Fumariaceae). Crop Prot. 2015, 67, 121–129. [Google Scholar] [CrossRef]
- Rosa, M.; Luca, L.; D’Avinoc, L.; Gilda, P. Nitrogen and carbon mineralization in soils amended with biofumigant or non-biofumigant plant materials. Ind. Crop. Prod. 2015, 75, 65–72. [Google Scholar]
- He, C.; Gong, B.; Wang, C.; Wang, X.; Wei, M.; Yang, F.; Li, Y.; Shi, Q. Studies on root-knot nematode control effect and its mechanism by biofumigation with Zanthoxylum bungeanum seed meal in tomato seedlings. Chin. Veg. 2016, 6, 64–70. (in Chinese). [Google Scholar]
- Zhang, C.; Gao, J.; Han, T.; Tian, X.; Wang, F. Integrated control of tobacco black shank by combined use of riboflavin and Bacillus subtilis strain Tpb55. BioControl 2017, 62, 835–845. [Google Scholar] [CrossRef]
- Dong, X. Study on the Extraction, Antioxidant and Antibacterial Activities of the Active Substances from Zanthoxylum bungeanum Seeds; Sichuan Agricultural University: Chengdu, China, 2016. (in Chinese) [Google Scholar]
- Wang, C.; You, C.; Yang, K.; Guo, S.; Geng, Z.; Fan, L.; Du, S.; Deng, Z.; Wang, Y. Antifeedant activities of methanol extracts of four Zanthoxylum species and benzophenanthridines from stem bark of Zanthoxylum schinifolium against Tribolium castaneum. Ind. Crop. Prod. 2015, 74, 407–411. [Google Scholar] [CrossRef]
- Han, X.; Zhao, J.; Cao, J.; Zhang, C. Essential oil of Chrysanthemum indicum L.: Potential biocontrol agent against plant pathogen Phytophthora nicotianae. Environ. Sci. Pollut. Res. 2019, 26, 7013–7023. [Google Scholar] [CrossRef] [PubMed]
- Han, T.; You, C.; Zhang, L.; Feng, C.; Zhang, C.; Wang, J.; Kong, F. Biocontrol potential of antagonist Bacillus subtilis Tpb55 against tobacco black shank. BioControl 2016, 61, 195–205. [Google Scholar] [CrossRef]
- Bao, S.D. Soil Agricultural Chemistry Analysis; China Agricultural Publishing House: Beijing, China, 2000. (In Chinese) [Google Scholar]
- Fabienne, G. Comparative 16S rDNA and 16S rRNA sequence analysis indicates that Actinobacteria might be a dominant part of the metabolically active bacteria in heavy metal- contaminated bulk and rhizosphere soil. Environ. Microbiol. 2003, 10, 896–907. [Google Scholar]
- Bokulich, N.A.; Subramanian, S.; Faith, J.J.; Gevers, D.; Gordon, J.I.; Knight, R.; Mills, D.A.; Caporaso, J.G. Quality-filtering vastly improves diversity estimates from Illumina amplicon sequencing. Nat. Methods 2013, 10, 57–59. [Google Scholar] [CrossRef]
- Caporaso, J.G.; Kuczynski, J.; Stombaugh, J.; Bittinger, K.; Bushman, F.D.; Costello, E.K.; Fierer, N.; Pena, A.G.; Goodrich, J.K.; Gordon, J.I.; et al. QIIME allows analysis of high-throughput community sequencing data. Nat. Methods 2010, 7, 335–336. [Google Scholar] [CrossRef]
- Edgar, R.C.; Haas, B.J.; Clemente, J.C.; Quince, C.; Knight, R. UCHIME improves sensitivity and speed of chimera detection. Bioinformatics 2011, 27, 2194–2200. [Google Scholar] [CrossRef]
- Hammer, K.A.; Carson, C.F.; Riley, T.V. Antifungal activity of the components of Melaleuca alternifolia (tea tree) oil. J. Appl. Microbiol. 2003, 95, 853–886. [Google Scholar] [CrossRef]
- Wang, L.; Wang, Z.; Li, X.; Zhang, H.; Zhou, X.; Zhang, H. Analysis of volatile compounds in the pericarp of Zanthoxylum bungeanum Maxim. By ultrasonic nebulization extraction coupled with headspace single-drop microextraction and GC-MS. Chromatographia 2010, 71, 455–459. [Google Scholar] [CrossRef]
- Zhang, W.; Tan, S.; Yang, J.; Liao, Q.; Lan, J.; Lv, Y.; Tang, J. Comparison of volatile components in fresh and dried Zanthoxylum bungeanum Maxim. Food Sci. Biotechnol. 2019, 28, 1083–1092. [Google Scholar] [CrossRef] [PubMed]
- Fu, L.; Xie, H.; Shi, S. Multielement analysis of Zanthoxylum bungeanum Matim. Essential oil using ICP-MS/MS. Anal. Bioanal. Chem. 2018, 410, 3769–3778. [Google Scholar] [CrossRef] [PubMed]
- Sriwichai, T.; Sookwong, P.; Siddiqui, M.W.; Sommano, S.R. Aromatic profiling of Zanthoxyhum myriacanthum (makwhaen) essential oils from dried fruits using different initial drying techniques. Ind. Crop. Prod. 2019, 133, 284–291. [Google Scholar] [CrossRef]
- Boeck, P.; Leal, P.C.; Yunes, R.A.; Filho, V.C.; López, S.; Sortino, M.; Escalante, A.; Furlán, R.L.E.; Zacchino, S. Antifungal activity and studies on mode of action of novel xanthoxyline-derived chalcones. Arch. Pharm. Chem. Life Sci. 2005, 338, 87–95. [Google Scholar] [CrossRef] [PubMed]
- Wen, M.G.; Zhang, X.B.; Tian, J.N.; Ni, S.; Bian, H.; Lin, Y.; Liang, H. Binding interaction of xanthoxylin with bovine serum albumin. J. Solut. Chem. 2009, 38, 391–401. [Google Scholar] [CrossRef]
- Pinto, E.; Gonçalves, M.J.; Hrimpenga, K.; Pinto, J.; Vaz, S.; Vale-Silva, L.A.; Cavaleiro, C.; Salgueiro, L. Antifungal activity of the essential oil of Thymus villosus subsp. lusitanicus against Candida, Cryptococcus, Aspergillus and dermatophyte species. Ind. Crop. Prod. 2013, 51, 93–99. [Google Scholar] [CrossRef]
- Espinosa-García, F.J.; Langenheim, J.H. Effects of sabinene and γ-terpinene from coastal redwood leaves acting singly or in mixtures on the growth of some of their fungus endophytes. Biochem. Syst. Ecol. 1991, 19, 643–650. [Google Scholar] [CrossRef]
- Glamoclija, J.; Sokovic, M.; Grubisic, D.; Vukojevic, J.; Milinekovic, I.; Ristic, M. Antifungal activity of Critmum maritimum essential oil and its components against mushroom pathogen Mycogone perniciosa. Chem. Nat. Comp. 2009, 45, 96–97. [Google Scholar] [CrossRef]
- Tampieri, M.P.; Galuppi, R.; Macchioni, F.; Carelle, M.S.; Falcioni, L.; Cioni, P.L.; Morelli, I. The inhibition of Candida albicans by selected essential oils and their major components. Mycopathologia 2005, 159, 339–345. [Google Scholar] [CrossRef]
- D’Auria, F.D.; Tecca, M.; Strippoli, V.; Salvatore, G.; Battinelli, L.; Mazzanti, G. Antifungal activity of Lavandula angustifolia essential oil against Candida albicans yeast and mycelial form. Med. Mycol. 2005, 43, 391–396. [Google Scholar] [CrossRef]
- An, P.; Yang, X.; Yu, J.; Qi, J.; Ren, X.; Kong, Q. α-terpineol and terpene-4-ol, the critical components of tea tree oil, exert antifungal activities in vitro and in vivo against Aspergillus niger in grapes by inducing morphous damage and metabolic changes of fungus. Food Control 2019, 98, 42–53. [Google Scholar] [CrossRef]
- Rahmana, M.A.; Whitelaw-Weckerta, B.O. Consecutive applications of brassica green manures and seed meal enhances suppression of Meloidogyne javanica and increases yield of Vitis vinifera cv. Semillon. Appl. Soil Ecol. 2011, 47, 195–203. [Google Scholar] [CrossRef]
- Hollister, E.B.; Hu, P.; Wang, A.S.; Hons, F.M.; Gentry, T.J. Differential impacts of brassicaceous and nonbrassicaceous oilseed meals on soil bacterial and fungal communities. FEMS Microbiol. Immunol. 2012, 83, 632–641. [Google Scholar] [CrossRef] [PubMed]
- Weerakoon, D.M.N.; Reardon, C.L.; Paulitz, T.C.; Izzo, A.D. Long-term suppression of Pythium abappressorium induced by Brassica juncea seed meal amendment is biologically mediated. Soil Biol. Biochem. 2012, 51, 44–52. [Google Scholar] [CrossRef]
- Yim, B.; Hanschen, F.S.; Wrede, A.; Nitt, H.; Schreiner, M.; Smalla, K.; Winkelmann, T. Effects of biofumigation using Brassica juncea and Raphanus sativus in comparison to disinfection using Basamid on apple plant growth and soil microbial communities at three field sites with replant disease. Plant Soil 2016, 406, 389–408. [Google Scholar] [CrossRef]
- Ma, L.; Zheng, S.C.; Zhang, T.K.; Liu, Z.; Wang, X.; Zhou, X.; Yang, C.; Duo, J.; Mo, M. Effect of nicotine from tobacco root exudates on chemotaxis, growth, biocontrol efficiency, and colonization by Pseudomonas aeruginosa NXHG29. Antonie Leeuwenhoek 2018, 111, 1237–1257. [Google Scholar] [CrossRef]
- Hu, P.; Hollister, E.B.; Somenahally, A.C.; Hons, F.M.; Gentry, T.J. Soil bacterial and fungal communities respond differently to various isothiocyanates added for biofumigation. Front. Microbiol. 2014, 5, 729. [Google Scholar] [CrossRef]
- Kuthubutheen, A.J.; Pugh, G.J.F. The effects of fungicides on soil fungal populations. Soil Biol. Biochem. 1979, 11, 297–303. [Google Scholar] [CrossRef]
- Galletti, S.; Sala, E.; Leoni, O.; Burzi, P.L.; Cerato, C. Trichoderma spp. tolerance to Brassica carinata seed meal for a combined use in biofumigation. Biol. Control 2008, 45, 319–327. [Google Scholar] [CrossRef]
- Lidor, O.; Dror, O.; Hamershlak, D.; Shoshana, N.; Belausov, E.; Zahavi, T.; Mozes-Daube, N.; Naor, N.; Zchori-Fein, E.; Iasur-Kruhh, L.; et al. Introduction of a putative biocontrol agent into a range of phytoplasma- and liberibacter-susceptible crop plants. Pest Manag. Sci. 2018, 74, 811–819. [Google Scholar] [CrossRef]
- Malinich, E.A.; Bauer, C.E. The plant growth promoting bacterium Azospirillum brasilense is vertically transmitted in Phaseolus vulgaris (common bean). Symbiosis 2018, 76, 97–108. [Google Scholar] [CrossRef]
© 2020 by the authors. Licensee MDPI, Basel, Switzerland. This article is an open access article distributed under the terms and conditions of the Creative Commons Attribution (CC BY) license (http://creativecommons.org/licenses/by/4.0/).